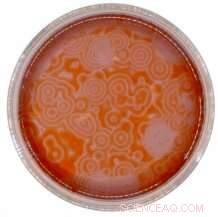
Decoding Chemical Wave Patterns in the Belousov–Zhabotinsky Reaction

Their project involved the Belousov–Zhabotinsky chemical reaction--an example of a chemical oscillator that is often used to illustrate a chaotic system. Credit: University of Exeter
A collaborative research project by team of undergraduate students from the University of Exeter's Natural Sciences department has been published in a prestigious academic journal.
Lewis Howell, Eleanor Osborne and Alice Franklin have had their second-year research published in The Journal of Physical Chemistry B.
Their paper, "Pattern Recognition of Chemical Waves: Finding the Activation Energy of the Autocatalytic Step in the Belousov-Zhabotinsky Reaction," was a result of their extended experiment work in the Stage 2 module "Frontiers in Science 2".
Their project involved The Belousov-Zhabotinsky Chemical Reaction—an example of a chemical oscillator that is often used to illustrate a chaotic system.
These reactions are theoretically important because they show that chemical reactions do not have to be dominated by equilibrium thermodynamic behavior.
For the research, the team used a Raspberry Pi camera to record images of the reaction over time, and repeated the experiment under a wide range of temperature conditions.
The group were the first to apply a filter-coupled circle finding algorithm and localized pattern analysis to the Belousov-Zhabotinsky reaction in order to extract features such as velocity of the waves.
They were soon able to get exceptionally good experimental results which, coupled with the application of novel image analysis techniques, allowed them to make unprecedented progress, unveiling some peculiar and previously undocumented features of this chemical oscillator.
Lewis said: "The experimental work went really well; we planned all the experiments ourselves and conducted them over five or six weeks of lab time. It's a really interesting chemical reaction, and we had a lot of fun doing it; we found that our data was really good, which gave us a good platform to work from.
"Together we were able to do a lot of cool analysis, using image processing techniques to extract properties such as the velocity of the chemical waves you see in the reaction."
Dr. Eric Hébrard, who co-supervised the module alongside Dr. David Horsell, said: "Throughout all this journey, Lewis, Eleanor and Alice have been very comfortable working alongside academic staff as well as together and have displayed engaging and collaborative team-working skills."
Alice added that "Natural Sciences at Exeter is geared towards giving undergraduate students first-hand experience of research." Eleanor also added that "without the course being so interdisciplinary, we couldn't have achieved such a high quality of results that enabled us to publish this paper; it goes to show that collaboration between scientists from different disciplines is a really effective way to approach research."